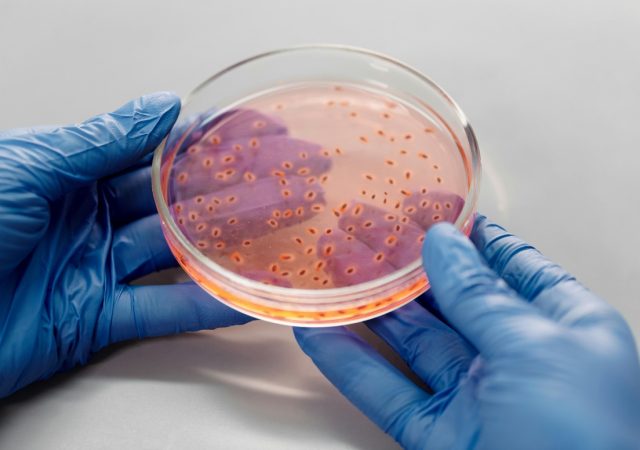

Potrivit unui studiu recent, 80% din caloriile arse în timpul acestei activități fizice provin direct din grăsime. Este mai mult decât un antrenament — este o strategie eficientă pentru remodelarea corporală și accelerarea metabolismului. Alegerea tipului potrivit de mișcare poate…
România Inteligentă ajunge la Bistrița: cultura și sportul, reperele unei comunități care inspiră
Pe 22 august 2025, Bistrița devine epicentrul unui dialog despre identitate, performanță și viitor. Sub egida proiectului România Inteligentă, conferința „Bistrița-Năsăud, Poarta Transilvaniei, drumul spre valori autentice prin cultură și sport” aduce în prim-plan forța comunității și potențialul regiunii de…
Renunțarea la micul dejun duce la îngrășare?
Pe măsură ce se apropie începutul toamnei, mulți oameni încearcă să scape de câteva kilograme acumulate în timpul verii. Între diete rapide, tendințe nutriționale și sfaturi transmise pe rețelele sociale, există o mie și una de metode prin care se…
Cancerul colorectal: simptomul tăcut care ne poate schimba destinul
Pe 3 noiembrie 2024, actorul James Van Der Beek, cunoscut pentru rolul său din serialul „Dawson’s Creek”, a făcut public faptul că a fost diagnosticat cu cancer colorectal. Într-un interviu acordat revistei People, Van Der Beek a vorbit deschis despre…
Avem doar 4.000 de săptămâni de viață. E timpul să renunți la „gestionarea timpului”
În cartea sa „4000 de săptămâni – Antimanual de gestionare a timpului pentru muritori”, autorul britanic Oliver Burkeman ne provoacă să privim timpul altfel: nu ca pe un lucru de controlat, ci ca pe un spațiu limitat în care să…
Încrederea în sine: o construcție interioară, nu o trăsătură înnăscută
Nu mai există nicio îndoială: într-o societate în care imaginea personală este filtrată prin lentilele rețelelor sociale, iar comparația devine un reflex zilnic, încrederea în sine pare mai degrabă o provocare decât o certitudine. Potrivit unui studiu citat de Psychologies,…
Laptele vegetal schimbă regulile sănătății
Pentru că alegerile alimentare devin tot mai conștiente, iar sănătatea metabolică și cardiovasculară este în centrul preocupărilor moderne, laptele vegetal nu mai este doar o opțiune pentru vegani sau persoane cu intoleranță la lactoză. Este o declarație de stil de…
Creatina: suplimentul legal care poate face mai mult decât să-ți crească masa musculară
Creatina este unul dintre cele mai studiate suplimente din lume. Cunoscută pentru efectele sale asupra performanței fizice, ea este adesea asociată cu sportivi, culturiști sau antrenamente intense. Însă un nou val de cercetări sugerează că beneficiile creatinei depășesc cu mult…
Vitamina K₂ din bacterii: descoperirea care poate revoluționa nutriția
Un nou studiu publicat recent în revista mBio dezvăluie modul în care o bacterie alimentară comună, Lactococcus lactis (L. lactis), poate fi modificată genetic pentru a produce în exces un precursor esențial în biosinteza vitaminei K₂ (menachinonă). Această descoperire deschide…
Ridurile de expresie: 5 metode aprobate de un expert pentru a le atenua vizibil
Ridurile zâmbetului, cunoscute și ca pliuri nasogeniene, sunt acele linii care pornesc din colțurile gurii și coboară spre bărbie. Deși sunt semne ale unei vieți pline de expresii și emoții, ele pot deveni vizibile chiar și în repaus, odată cu…